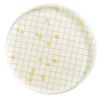
MB000000T.jpg

* Imagem meramente ilustrativa
MEIO TGE CALDO DESIDRATADO PÓ FRASCO COM 113,5g PARA CONTAGEM TOTAL DE BACTERIAS (EMB) MILLIPORE
Modelo: MB000000T
R$ 1.806,47
ou até 3x de R$ 602,16 sem juros
Economize 5% no PIX: R$ 1.716,15
ou 3,5% no boleto: R$ 1.743,24
Calcular Frete
Descrição
MEIO TGE CALDO DESIDRATADO PÓ FRASCO C/113,5g MILLIPORE
P/CONTAGEM TOTAL DE BACTERIAS
Tryptone Glucose Extract Broth (Dehydrated).
Pó seco contendo Glucose, Tryptone, e Meat Extracts, Beef
Descrição: Caldo Standard Plate Count/ Tryptone Glucose Extract (Desidratado)
Aplicações: Microbiologia de águas
Principais aplicações:
Cerveja
Água engarrafada
Cidra
Laboratório clínico
Cosméticos
Análise ambiental
Monitoramento ambiental
Alimentos e bebidas
QC industrial
Filtração para laboratórios
Refrigerantes
Bebidas esportivas
Monitoramento da água
Vinho
Conformidade Regulamentar: Standard Methods for Examination of Water and WasteWater- Standard Plate count
Meio: TGE
Dispositivo Aplicável: Método MF / Milliflex
Aparência do organismo: Colônias são transparentes, ou brancas e cremosas, algumas podem produzir pigmento
Temperatura de incubação, °C: 28-35
Forma do meio: desidratado
pH @ 25°C: 7.0 ± 0.2
Condições de Armazenagem: Temperatura Ambiente
Embalagem: frasco com tampa de rosca
Microrganismos-alvo: Contagem total
Nome do produto: Caldo Standard Plate Count/ Tryptone Glucose Extract (Desidratado)
Prazo de validade (meses): 60
Cor do Meio: Ligeiramente âmbar/amarelo, transparente a incolor
Tempo de incubação, h: 48-96
